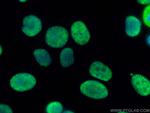
DHX9 Antibody in Immunocytochemistry (ICC/IF)

Search
Proteintech
DHX9 Polyclonal Antibody, CoraLite® Plus 488
{{$productOrderCtrl.translations['antibody.pdp.commerceCard.promotion.promotions']}}
{{$productOrderCtrl.translations['antibody.pdp.commerceCard.promotion.viewpromo']}}
{{$productOrderCtrl.translations['antibody.pdp.commerceCard.promotion.promocode']}}: {{promo.promoCode}} {{promo.promoTitle}} {{promo.promoDescription}}. {{$productOrderCtrl.translations['antibody.pdp.commerceCard.promotion.learnmore']}}
产品信息
CL488-17721
种属反应
宿主/亚型
分类
类型
抗原
偶联物
激发/发射光谱
形式
浓度
规格
纯化类型
保存液
内含物
保存条件
运输条件
产品详细信息
Immunogen sequence: MGDVKNFLY AWCGKRKMTP SYEIRAVGNK NRQKFMCEVQ VEGYNYTGMG NSTNKKDAQS NAARDFVNYL VRINEIKSEE VPAFGVASPP PLTDTPDTTA NAEGDLPTTM GGPLPPHLAL KAENNSEVGA SGYGVPGPTW DRGANLKDYY SRKEEQEVQA TLESEEVDLN AGLHGNWTLE NAKARLNQYF QKEKIQGEYK YTQVGPDHNR SFIAEMTIYI KQLGRRIFAR EHGSNKKLAA QSCALSLVRQ LYHLGVVEAY SGLTKKKEGE TVEPYKVNLS QDLEHQLQNI IQELNLEILP P
靶标信息
The human alanyl-tRNA synthetase (AARS) belongs to a family of tRNA synthases, of the class II enzymes. Class II tRNA synthases evolved early in evolution and are highly conserved. This is reflected by the fact that 498 of the 968-residue polypeptide human AARS shares 41% identity witht the E.coli protein. tRNA synthases are the enzymes that interpret the RNA code and attach specific aminoacids to the tRNAs that contain the cognate trinucleotide anticodons. They consist of a catalytic domain which interacts with the amino acid acceptor-T psi C helix of the tRNA, and a second domain which interacts with the rest of the tRNA structure.
仅用于科研。不用于诊断过程。未经明确授权不得转售。
篇参考文献 (0)
生物信息学
蛋白别名: ATP-dependent RNA helicase A; D-E-A-D (aspartate-glutamate-alanine-aspartate) box polypeptide 9; DEAD (aspartate-glutamate-alanine-aspartate) box polypeptide 9; DEAD/H (Asp-Glu-Ala-Asp/His) box polypeptide 9; DEAH (Asp-Glu-Ala-His) box helicase 9; DEAH (Asp-Glu-Ala-His) box polypeptide 9; DEAH box protein 9; DEAH-box helicase 9; DExH-box helicase 9; FLJ17406; Leukophysin; LKP; mHEL-5; NDH II; Nuclear DNA helicase II; OTTHUMP00000033287; RHA; RNA helicase; RNA helicase A; unnamed protein product
基因别名: AI326842; DDX9; DHX9; HEL-5; LKP; mHEL-5; MRD75; NDH2; NDHII; RHA
UniProt ID: (Human) Q08211, (Mouse) O70133
Entrez Gene ID: (Human) 1660, (Mouse) 13211, (Rat) 304859